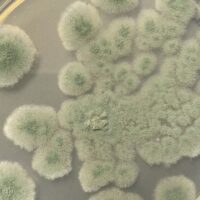

Этот астероид просуществовал 4 миллиарда лет. Это может быть огромной проблемой

Огромное количество камней и других материалов летает по Солнечной системе в виде астероидов и комет. Если бы один из них приблизился к нам, смогли бы мы успешно предотвратить столкновение астероида с Землей?
Ну, может быть. Но, похоже, есть один тип астероидов, который особенно трудно уничтожить.
Астероиды — это куски каменистых обломков в космосе, остатки более жестокого прошлого в нашей Солнечной системе. Изучение их может раскрыть их физические свойства, подсказки о древней истории Солнечной системы и угрозах, которые эти космические камни могут представлять при столкновении с Землей.
В нашем новом исследовании, опубликованном сегодня в Proceedings of the National Academy наук, мы обнаружили, что астероиды из обломков являются чрезвычайно устойчивым типом астероидов и их трудно разрушить при столкновении.
Два основных типа астероидов
Астероиды, в основном сосредоточенные в поясе астероидов, можно разделить на два основных типа.
Монолиты, состоящие из цельного куска породы, — это то, что люди обычно имеют в виду, когда думают об астероидах.
Астероиды монолитного типа о Было предсказано, что продолжительность жизни километрового диаметра в поясе астероидов составит всего несколько сотен миллионов лет. Это совсем немного, учитывая возраст нашей Солнечной системы.
Другой тип — это астероиды из груды щебня. Они полностью состоят из множества фрагментов, выброшенных во время полного или частичного разрушения ранее существовавших монолитных астероидов.
Однако мы на самом деле не знаем прочности и, следовательно, потенциальной продолжительности жизни груды щебня. астероиды.
Подлые и многочисленные груды обломков
В сентябре 2022 года миссия NASA DART (Double Asteroid Redirection Test) успешно столкнулась с астероидом Диморфос. Цель этой миссии состояла в том, чтобы проверить, сможем ли мы отклонить астероид, столкнувшись с ним с помощью небольшого космического корабля, и она увенчалась ошеломляющим успехом.
Как и другие недавние миссии астероидов, проведенные Японским агентством аэрокосмических исследований (JAXA). Чтобы посетить астероиды Итокава и Рюгу, а НАСА — к астероиду Бенну, изображения крупным планом показали, что Диморфос — это еще один астероид из груды щебня.
Эти миссии показали нам, что астероиды из щебня имеют низкую плотность, потому что они пористые. К тому же они в изобилии. На самом деле их очень много, и, поскольку они представляют собой осколки монолитных астероидов, они относительно малы, и поэтому их трудно обнаружить с Земли.
Поэтому такие астероиды представляют серьезную угрозу для Земли, и нам действительно нужно лучше их понимать.

Уроки астероидной пыли
В 2010 году космический корабль «Хаябуса», разработанный JAXA, вернулся с 535-метрового астероида Итокава в форме арахиса. Зонд принес с собой более тысячи частиц камней, каждая из которых меньше песчинки. Это были первые в истории образцы, доставленные с астероида!
Как потом выяснилось, снимки, сделанные космическим кораблем «Хаябуса», когда он еще находился на орбите Итокавы, впервые продемонстрировали существование астероидов, состоящих из обломков. .
Предварительные результаты группы JAXA, которая проанализировала возвращенные образцы, показали, что Итокава образовался после полного разрушения родительского астероида, размер которого составлял не менее 20 километров.
В нашем новом исследовании , мы проанализировали несколько частиц пыли, вернувшихся с астероида Итокава, используя два метода: первый из них запускает электронный луч в частицу и обнаруживает электроны, которые рассеиваются обратно. Он сообщает нам, подверглась ли порода удару какого-либо метеорита.
Второй метод называется аргон-аргоновым датированием и использует лазерный луч для измерения количества радиоактивного распада, произошедшего в кристалле. Это дает нам возраст такого падения метеорита.
Гигантские космические подушки, которые существуют вечно
Наши результаты показали, что огромное столкновение, которое разрушило родительский астероид Итокавы и сформировало Итокава, произошло более 4,2 лет назад. миллиард лет назад, что почти так же старо, как и сама Солнечная система.
Этот результат был совершенно неожиданным. Это также означает, что Итокава прожил почти на порядок дольше, чем его монолитные аналоги.
Такое удивительно долгое время выживания астероида объясняется его амортизирующей природой. Из-за того, что Итокава представляет собой груду щебня, пористость составляет около 40 процентов.
Другими словами, почти половина ее состоит из пустот, поэтому постоянные столкновения будут просто разрушать промежутки между камнями, а не разрушать их. сами скалы.
Итак, Итокава подобен гигантской космической подушке.
Этот результат указывает на то, что астероидов из груды булыжников в поясе астероидов гораздо больше, чем мы когда-то думали. Как только они образуются, их очень трудно уничтожить.
Эта информация имеет решающее значение для предотвращения любого потенциального столкновения астероида с Землей. В то время как миссия DART успешно подтолкнула орбиту астероида, на который она нацелилась, передача кинетической энергии между небольшим космическим кораблем и астероидом, состоящим из обломков, очень мала. Это означает, что они по своей природе устойчивы к разрушению в случае удара.
Поэтому, если Земле угрожает неминуемая и непредвиденная угроза в виде приближающегося астероида, нам нужен более агрессивный подход.
p>
Например, нам может понадобиться использовать ударную волну ядерного взрыва в космосе, так как большие взрывы могут передать гораздо больше кинетической энергии астероиду из кучи щебня с естественной амортизацией и, таким образом, оттолкнуть его. p>
Должны ли мы на самом деле испытать метод ядерной ударной волны? Это совсем другой вопрос. » alt=»The Conversation» width=»1″ height=»1″ style=»border: none !important; box-shadow: none !important; margin: 0 !important; max-height: 1px !important; max- ширина: 1px !важно; минимальная высота: 1px !важно; минимальная ширина: 1px !важно; непрозрачность: 0 !важно; контур: нет !важно; отступы: 0 !важно;» referrerpolicy=»no-referrer-when-downgrade»>
Фред Журдан, профессор Кертинского университета, и Ник Тиммс, доцент Кертинского университета
Эта статья переиздается из The Conversation под лицензией Creative Commons. Прочтите исходную статью.